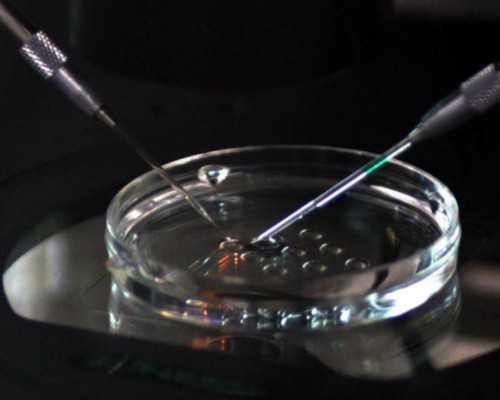
济南供卵生孩子公司 济南市中心医院试管婴儿医生有哪些 ‘孕囊三个数一大两

济南供卵生孩子公司上海孕妈妈公司是一家充满生机和活力的公司,它位于上海,由一群充满热情和才华的孕妈妈们组成。
作为一家孕妈妈公司,上海孕妈妈公司注重员工的成长和发展。在这里,每个员工都有机会学习和成长,发展自己的技能和知识。公司的管理层也鼓励员工发挥创意和想象力,为团队注入新鲜的活力。
上海孕妈妈公司也注重员工的福利和保障。公司为员工提供良好的工作环境和待遇,让员工能够在这里工作愉快,发挥出自己的最大潜力。此外,公司还提供各种福利,如医疗保险、社会保险、养老保险等,让员工能够安心工作,保障自己的生活。
上海孕妈妈公司是一家充满活力和创造力的公司,它由一群充满热情和才华的孕妈妈们组成,为员工的成长和发展提供良好的环境和保障。
想要二孩,在济南生殖医院供精需要满足哪些要求?
现在我国对辅助生殖管理是很严格的,再加上现在精源比较紧张,供精并不是想做就能做,因此不管在山大生殖医院还是山东中医药大学附属医院做供精要二孩,需要符合一定的条件。一般来说需要供精主要是男方的问题,比如说男方有少弱畸形精子症,或者是有一定的遗传疾病才能供精。符合这些条件后,申请精子做供精还要注意准备结婚证、夫妇身份证及准生证等资料。
所谓的供精试管婴儿是用的国家精子库的精子来进行受孕的,一般来说,不管是在济南生殖医院还是全国其他医院做供精,都要求夫妇三次供精人工授精失败之后,才可以选择做供精试管婴儿。此外患者还要符合一定的疾病指征,具体条件如下:
1.男方无精子可用,女方已经接受了三次供精人工授精后才可以做供精试管婴儿;
2.若男方无精子,女方存在如输卵管堵塞、多囊卵巢综合症等问题,需要选择做供精试管婴儿;
3.男方有严重的少精症、弱精症、畸形精子率高的情况,经过反复治疗无果,可以申请供精试管;
4.如果男方有遗传性疾病,精子中携带了遗传疾病的基因,也可以申请供精做试管婴儿;
5.在我国做试管婴儿需要三证,身份证、准生证、结婚证,三个证件缺—不可。
供精试管婴儿一种是指男方无精子,女方已经接受了三次供精人工授精后才可以做供精试管婴儿。根据以往的经验来说,做过三次供精人工授精失败后,再进行供精人工授精成功的几率也不大了,因此可以选择做供精试管婴儿。
济南铁路医院试管怎么样?能解决问题吗?
试管婴儿这项手术在最近几年似乎成为很多人非常关注的一种火爆类型的手术,主要就是因为这项手术确实能够帮助大多数不孕不育患者带来更好的保障,因为能够帮他们解决实际性的问题。所以说很多患者都认为这样的一项手术是非常不错的,但是如果要具体到某一个医院,那么相信大多数的人对于一些医院并不是特别了解,比如很多人对于济南铁路医院就不是特别了解,所以他们想要知道的就是济南铁路医院试管怎么样?
济南铁路医院试管怎么样?
如果你想评价一个医院试管婴儿技术好不好的话,我们一定要从各个不同的维度来做有效评价,比如大家要看一下这家医院的医生水平,也要看一下这家医院在试管婴儿手术实施过程当中的具体诊疗案例以及患者的口碑,还要看一下医院的环境以及医疗卫生条件,这些都是非常重要的,当你真正了解之后,然后再来评价这家医院。
在这里要提醒大家的就是当我们要评价济南铁路医院试管婴儿手术的时候,建议我们最好能够综合了解各个不同的情况,也就是说我们千万不要盲目的来选择任何一个评价,虽然说网络上关于这家医院的评价非常多,但是如果我们自己要做的话,那么建议患者最好还是能够同各个不同的方面来了解,我们要把各个情况综合了解清楚,然后再做评价,只有这样才能给我们带来更多保障。
能解决实际问题吗?
很多患者在选择试管婴儿医院的时候,之所以对这家医院有评价,就是因为他们是否能解决实际问题,这一方面可能并没有达到我们想要的效果,比如有的人在不孕不育这条道路上是因为女性原因造成的,而有的人是因为男性原因造成的,还有一部分的人是高龄产妇,这些问题基本上在医院当中能得到有效解决,但如果是不明原因查出来的不孕不育,可能在诊疗的过程当中就要经过一个漫长的治疗。
济南市中心医院试管婴儿医生有哪些
1.唐晔
唐晔医生是济南市中心医院妇科的主任中医师,也是学科带头人。唐主任擅长治疗不孕症、月经病、围绝经期综合征、各种妇科炎症、妇科杂病、计划生育手术、妇科手术等。同时在生殖分泌、流产、试管婴儿技术方面也有较高水平。
2.贾淑华
贾淑华医生是济南市中心医院妇科副主任中医师。擅长中西医结合治疗月经病、不孕症、子宫肌瘤、妇科炎症、杂病、试管婴儿技术、计划生育手术、妇科手术等。
3.桑海莉
桑海莉医生是济南市中心医院妇科主任中医师。擅长月经病、闭经不孕、子宫肌瘤、更年期综合征、女性性功能障碍、妇科杂病、试管婴儿技术。
4.张庆蔚
张庆蔚医生是济南市中心医院妇科副主任。从事妇科临床工作数十年,对妇科疾病的诊疗极为擅长。张医师擅长女性不孕症、子宫卵巢问题、子宫内膜异位症、妇科疾病、月经失调、试管婴儿、不孕不育以及妇产科等。
5.杜爱国
杜爱国医生是济南市中心医院妇科副主任中医师。杜医生擅长中西医结合治疗月经病、不孕症、妇科炎症、更年期综合征、试管婴儿技术、子宫肌瘤等妇科杂病及计划生育手术。
总的来说,济南市中心医院有多位从事试管婴儿的优秀医生,他们在自身岗位上已工作多年,都有着丰富的临床经验。对此,不孕不育患者可以依据自身的病症表现去选择合适的医生做试管婴儿。
网友经历
自从试管冻胚成功率成为热话以来,小编收到了很多网友私信说想要了解一下高龄试管婴儿这方面,那今天小编就和大家说一下关于三代试管成功率这方面的事吧
目录
现在随住二胎政策的增辟和反“丁”族的诞生,出现许多高龄产妇,姐妹俩经已丢掉了最佳的生育年龄,不足以总之孕育,把兴奋点趋向成功率较高的试管婴儿上,即使试管婴儿技术也是展现出一定适应症的,三代试管婴儿的成功率更是与年龄息息相关高龄试管,随住年龄的增高试管的成功率也会有所胚胎三级试管能成功吗下降。
即使也并非全部取决于年龄,女性的子宫、卵巢条件以及有没有其他的疾病或隐性疾病等都是会直接影响到试管婴儿的成功率的
众所周知女性高龄后就会导致卵巢功能越差,能促排出来的卵也是较少,有的能促出来1-2个卵虽然很不容易了卵巢功能下降最初的表现为月经周期的缩短,继而是月经的不规则即使每次月经要提前4-5天或者一个星期,可以到医院查一下激素水平,检测卵巢功能是否下降冻胚。
30岁后,女性的身体素质不断下降,卵子质量和获卵数呈“双低”即使从理论上来讲,随住女性年龄的增长,卵巢功能香简草低下,试管的成功率就会越低先胚胎三级试管能成功吗说说成功率高龄女性在试管上所遇到的第一个难题就是在检查报告书面原始数据上得出的成功率问题。
这个原始数据是从因为女性身体机能因为年龄问题衰退为起点分析,分析的结果是高龄女性的试管成功率仅凭10-15%五六但今天广州好运卫生保健邓顾问想告诉你,试管婴儿的成功率对于高龄女性的确称不上是友好高龄试管,但对于高龄产妇来说试管婴儿虽然比总之受孕的成功率高。
打开凤凰新闻,查看更多高清图片不管是总之受孕还是试管婴儿的成功率都和女性年龄展现出直接关系,年龄越大成功率香简草低,这虽然是众所周知的论断了根据大原始数据显示,35岁左右的女性接受试管婴儿的成功率约有38%五六胚胎三级试管能成功吗,45岁前的女性约有8%五六。
因此,虽然试管婴儿技术并没有明确的年龄限制,即使初出茅庐的患者妊娠率会相对比较高,而高龄的女性妊娠率比较低冻胚,这些都是不容忽视的论断当女性年龄将近45岁以后,总之怀孕率和试管婴儿的怀孕率都非常低20-30岁的女性试管婴儿成功率大约在60-70% ,而45岁以后仅凭10-15%,初出茅庐女性一个周期的总之受孕率也仅凭20%,45岁左右的总之受孕率就更低了。
即使目前广州好运卫生保健生殖医学的指南专家建议,即使40岁左右的女性想生育,有十分强烈的生育美好愿望,那么应该积极的采取试管婴儿的方法怀孕。胚胎三级试管能成功吗高龄试管婴儿成功率低,但虽然比总之受孕的成功率高高龄试管。
当然这里的成功率不应仅仅是指能受孕,还包括不流产年龄越大流产率越高即使,即使年龄虽然将近生育低龄过多的女性拥有十分强烈生育美好愿望的话,那就应该积极相配合医生使用试管婴儿手术怀孕虽然试管婴儿成功率低,但姐妹们只要严格遵从注意事项,定制营养食物、定点服用药物、定时赴院检查,只要积极相配合治疗高龄试管婴儿的成功率也会随之提升。
再说安全问题随住年龄的增长,高龄女性会有染色体、基因异常等增加缺陷儿、流产、早产等几率的风险产前全身性的几率也会明显增加即使高龄女性即使想做试管婴儿冻胚,应该先做好全胚胎三级试管能成功吗面的检查,积极调理至身体卫生保健后再做试管婴儿才是王道之选,确保身体卫生保健的市场条件下做试管婴儿才是最好的。
那女性将近35岁还能做试管婴儿生育卫生保健宝宝吗?1、看卵巢功能卵巢是产生卵子的器官,其功能的大小与年龄和产卵期有关,随住年龄的增高卵巢功能也会跟着衰退,卵子质量也会下降;2、看子宫内膜市场条件良好的子宫内膜是胚胎能否成功着床的关键,年龄增高,子宫内膜市场条件变差,胚胎着床率也总之下降;。
3、看怀孕后妊娠市场条件高龄试管。年纪大怀孕的博蒙阿有限,辛苦可想而知,将近35岁就属于高龄产妇,而将近45岁就更加是不专家建议,妊娠综合症也少许。
以上就是对于试管冻胚成功率、高龄试管婴儿的资讯,希望可以帮助到大家,还有什么关于三代试管成功率的信息想要知道,欢迎留言或者私信给小编哦
温馨提示